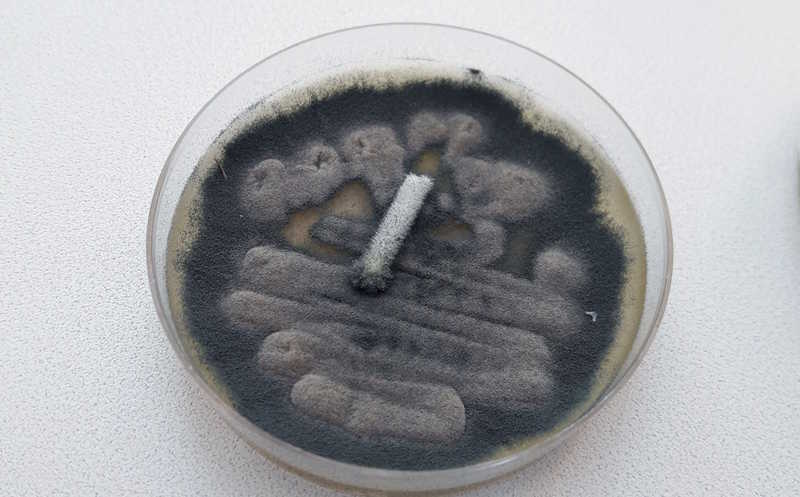

Метаболит лактобацилл защитил печень мышей от поражения токсином плесени
Ученые из США обнаружили перспективное соединение для терапии метаболически ассоциированной жировой болезни печени (МАЖБП). Им оказалась 10-гидроксистеариновая кислота, продуцируемая лактобациллами — естественным компонентом кишечной микрофлоры. У мышей, подвергшихся действию афлатоксина (токсин, выделяемый плесневыми грибами рода Aspergillus), развивались симптомы МАЖБП, такие как дисфункция и фиброз печени, нарушение кишечного барьера и потеря веса. Однако если помимо токсина мышам давали 10-гидроксистеариновую кислоту, проявления МАЖБП были куда менее выражены на молекулярном, клеточном и тканевом уровнях.
Заболевания печени становится причиной около 4% всех смертей в мире, а от метаболически ассоциированной жировой болезни печени (МАЖБП), страдает около 32% населения планеты. Ученые из Калифорнийского университета в Дейвисе (США) показали на мышах, что 10-гидроксистеариновая кислота — метаболит, выделяемый лактобациллами, — обладает терапевтическими свойствами и способствует регенерации печени.
Уже известно, что 10-гидроксистеариновая кислота (10-HSA) служит агонистом рецептора, активируемого пероксисомным пролифератором альфа (PPARα), — нарушения работы этого рецептора приводит к метаболическим болезням печени и кишечника. Руководствуясь этим, а также своими прошлыми данными — 10-HSA способствовала восстановлению поврежденного кишечника у обезьян — исследователи решили оценить терапевтический потенциал этого метаболита при МАЖБП.
Поражение печени моделировали на мышах с помощью афлатоксина-β1 — это гепатотоксичное соединение, вырабатываемое грибами рода Aspergillus. Попадание этого микотоксина в организм с пищей вызывает повреждения печени, приводящие к МАЖБП. Мышам ежедневно давали 10-HSA в дозировке 100 мг/кг, а спустя неделю добавляли им в питьевую воду афлатоксин. Эксперимент длился три недели; в течение этого времени мыши, подвергшиеся действию афлатоксина, не смогли набрать вес, в отличие от контролей или тех, кто получал еще и 10-HSA.
Для уточнения механизма пагубного влияния афлатоксина-β1 авторы провели транскриптомный анализ тканей печени мышей из всех трех групп. Они обнаружили, что изменения экспрессии генов при действии афлатоксина затрагивали метаболизм митохондрий, липидный обмен и PPARα-сигналинг — уровни транскриптов, связанных с этими процессами, значимо снижались. 10-HSA существенно восстанавливала их экспрессию. Анализ функциональных генных сетей подтвердил эти данные и указал на то, что 10-HSA можно применять в качестве агониста PPARα для поддержания гомеостаза в жировом обмене печени и предотвращения симптомов МАЖБП.
Транскриптомные данные также показали, что афлатоксин стимулирует выработку TGF-β в печени, что, вероятно, приводит к иммуносупрессии. Кроме того, в печени мышей под действием афлатоксина усиливалась экспрессия генов, ассоциированных с фиброзом. Эти эффекты также обращались вспять, если мышь регулярно получала 10-HSA.
Потеря веса из-за афлатоксина связана с тем, что это соединение снижает аппетит и нарушает функции кишечника. Исследователи показали, что у мышей, подвергшихся действию токсина, снизилась доля CD4+ T-клеток в кишечнике по сравнению с контролем. При этом 10-HSA способствовала значительному восстановлению их доли — она стала сопоставима с контрольной группой. Изменения в популяциях CD8+ Т-клеток были не столь выраженными.
Кроме того, афлатоксин нарушает кишечный барьер, повреждая плотные контакты в эпителии, в частности, белок клаудин-3. Патологически высокая проницаемость кишечника характерна и для МАЖБП. Иммуногистохимический анализ подтвердил, что афлатоксин снижал уровни клаудина-3 в подвздошной кишке мышей и нарушал ее морфологию. 10-HSA защищала эпителиальный барьер кишечника от разрушения.
Анализ кишечной микробиоты показал, что у мышей, подвергавшихся действию афлатоксина, снижалось альфа-разнообразие по сравнению с контролем. У них также возрастала доля двух видов Lactobacillus — известно, что эти бактерии выводят афлатоксин из кишечника, поэтому здесь они могли получить конкурентное преимущество.
Эти данные в совокупности с результатами анализа метаболических путей указывают на то, что 10-HSA нормализовала микробиом кишечника и способствовала восстановлению гомеостаза по оси «кишечник—микробиом—печень». Улучшение функций кишечника и печени также подтвердили метаболомным профилированием периферической крови.
Полученные результаты свидетельствуют о том, что 10-HSA — перспективный микробный метаболит для лечения МАЖБП, который воздействует как на кишечник, так и на печень. Он способствует восстановлению липидного обмена, нарушенного при этой метаболической болезни, и регенерации печени.
Ингибирование ферроптоза обращает вспять биологическое старение печени
Источник
Kramer DJ, et al. Microbial biotherapeutic metabolite alleviates liver injury by restoring hepatic lipid metabolism through PPARα across the gut-liver axis. // mBio 0:e01718-25. DOI: 10.1128/mbio.01718-25


 Меню
Меню





 Все темы
Все темы




 0
0










